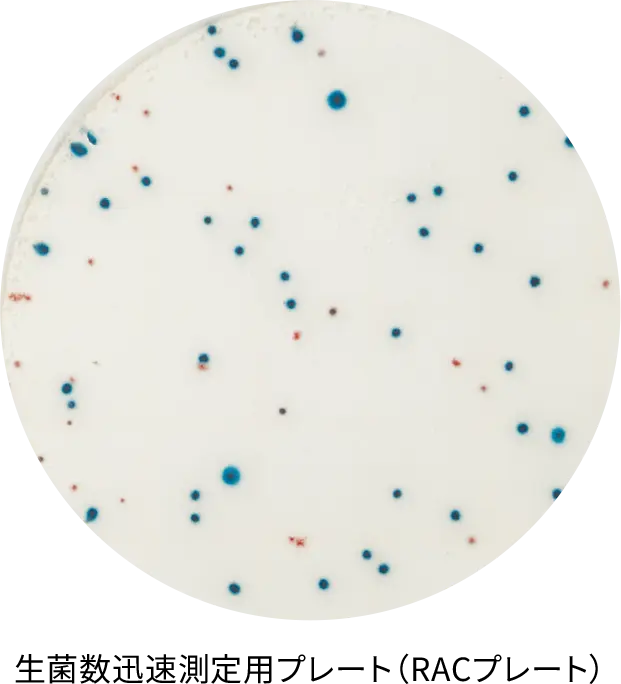
生菌数迅速測定用プレート（RACプレート）
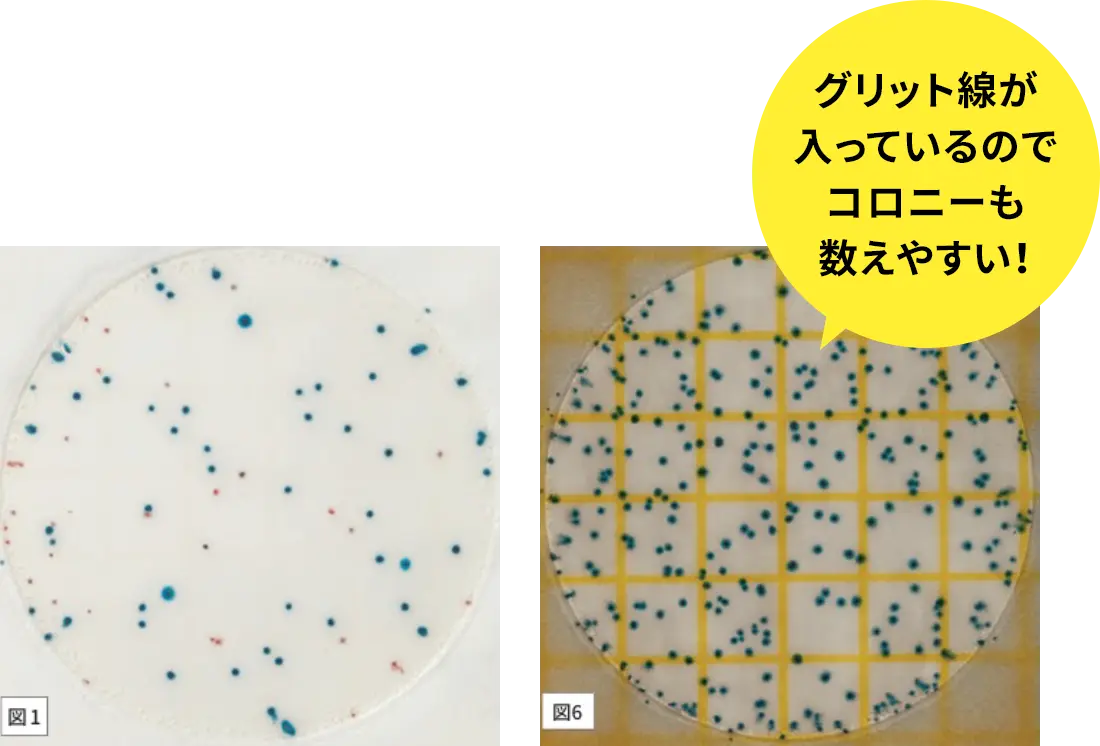
グリット線が入っているのでコロニーも数えやすい！

Point.1
正確性
人によるバラつきを抑えることが可能
一般的な微生物検査で使用される寒天培地と異なり、培地の調製が不要です。
また、検体準備後、「接種」「培養」「測定」のシンプルな3ステップのため、検査員による検査結果のバラつきを抑えることができます。






ペトリフィルム™ 培地は、食品・飲料・環境検査において、従来の寒天培地に代わる画期的な製品として世界的に高い評価を得ている乾式フィルムの簡易培地です。
培地調製不要で、微生物検査の効率化・標準化に貢献します。
1984年の発売以来、「準備の手間なく誰でも簡単に使用できる」ことから、多くのお客様に支持され、これまでに世界中の食品製造業、検査機関等で、のべ28億5000万枚以上のペトリフィルム™ 培地をご活用いただいております。
ペトリフィルム™ 培地は、3Mが展開していたフードセーフティ製品事業をNeogenが統合し、現在はNeogenブランドとして製造・販売している製品です。
一般生菌検査をはじめ、大腸菌群、大腸菌(E.coli)、腸内細菌科菌群、カビ・酵母、乳酸菌、黄色ブドウ球菌、リステリア属菌、サルモネラ属菌、セレウス菌など、食品衛生管理に必要な各種微生物検査に対応しています。

Point.1
一般的な微生物検査で使用される寒天培地と異なり、培地の調製が不要です。
また、検体準備後、「接種」「培養」「測定」のシンプルな3ステップのため、検査員による検査結果のバラつきを抑えることができます。



Point.2
ペトリフィルム™ 培地の迅速判定シリーズは、従来の寒天培地法※に比べ、培養時間を50%短縮することができます。
検査室の作業効率化はもちろん、結果判定までの時間が短縮できることで、他部門や会社全体にもメリットを提供することも可能です。
参考:食品衛生検査指針 微生物編 改訂第2版 2018。対象菌種は一般生菌、大腸菌群、E.coli、黄色ブドウ球菌カビ・酵母サルモネラ。


Point.3
ペトリフィルム™ 培地シリーズには、それぞれコロニーを見やすくする発色指示薬が含まれています。
これによりコロニーが着色されて検出するため、寒天培地と比較し見分けやすくなっています。
Point.4
ペトリフィルム™ 培地は、世界65カ国以上で使用され、200以上の認証推薦※された信頼性の高い検査法です。
また、そのほとんどの製品が妥当性確認された検査法として第三者認証機関に認証されており、日本国内においては「食品衛生検査指針 微生物編 改訂第2版 2018」に収載されています。
ネオジェンジャパン 食品衛生検査関連製品 第三者認証一覧はこちらをご覧ください。

Point.5
ペトリフィルム™ 培地シリーズは、簡易培地であるため培地調製の時間はもちろん、混釈や培養、片付けといった一連の作業を大幅にカットできます。
さらに使いたい時にすぐ使えるので、急な検査依頼にも臨機応変に対応することができます。


ペトリフィルム™ 培地には、一般生菌、大腸菌群、黄色ブドウ球菌、カビ・酵母など、主要な検査項目がすべて揃っています。検査法をペトリフィルム™ 培地に統一することで、資材管理やトレーニングが一本化され、業務効率が向上します。以下、ペトリフィルム™ 培地の製品ラインナップをご確認いただけます。


ペトリフィルム™ 培地の導入により、労務コストは最大44%削減、検査員の作業効率は最大80%向上したというデータがあります。さらに、廃棄物の量や保管スペースの大幅な削減など、サステナビリティの観点でも大きな貢献が期待できます。検査が楽になるだけでなく、会社全体の利益や環境活動にもつながるのです。

![]()

Contact Us
製品の導入・その他お問い合わせはこちらから